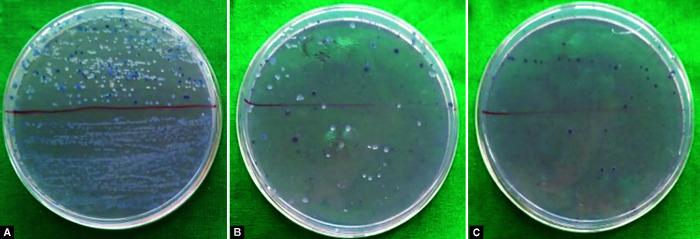

洗必泰和草药漱口水对混合牙列期儿童唾液的抗菌效果:一项随机交叉研究。
Antimicrobial Efficacy of Chlorhexidine and Herbal Mouth Rinse on Salivary in Children with Mixed Dentition: A Randomized Crossover Study.
作者信息
Shah Shreyas V, Badakar Chandrashekhar M, Hugar Shivayogi M, Hallikerimath Seema, K Gowtham, Mundada Madhura V
机构信息
Department of Paediatric and Preventive Dentistry, KAHER's KLE VK Insitute of Dental Sciences, Belagavi, Karnataka, India.
Department of Oral and Maxillofacial Pathology and Oral Microbiology, KAHER's KLE VK Insitute of Dental Sciences, Belagavi, Karnataka, India.
出版信息
Int J Clin Pediatr Dent. 2022 Jan-Feb;15(1):99-103. doi: 10.5005/jp-journals-10005-2348.
AIM AND OBJECTIVE
() shows increased resistance to currently available antibiotics and chemotherapeutics. The present study compares the effectiveness of chlorhexidine and Herbal mouth rinse against salivary in children with mixed dentition.
MATERIALS AND METHODS
Subjects ( = 60) with mixed dentition were selected for the study. Caries status was recorded using Nyvard's criteria. Baseline saliva samples were collected and assessed for quantifying . Subjects were instructed to rinse their mouths with 0.2 % w/v chlorhexidine and herbal mouth rinse for 7 days. Saliva samples were collected after 7 days and assessed for . After a run-in period of 21 days, both the mouth rinses were crossed over according to the Latin square design, and a similar procedure was carried out. Later, determination of mean colony-forming units (CFU/mL) from the saliva samples was done. For statistical analysis, Kolmogorov and Mann-Whitney tests were applied.
RESULTS
Both the groups showed a significant reduction in count, at baseline and 7 days ( = 0.0001), and the reduction of count in herbal mouth rinse as compared to chlorhexidine mouth rinse ( = 0.0209) was statistically significant.
CONCLUSION
Herbal mouth rinse proved to have better antimicrobial efficacy than Chlorhexidine mouth rinse.
HOW TO CITE THIS ARTICLE
Shah SV, Badakar CM, Hugar SM, Antimicrobial Efficacy of Chlorhexidine and Herbal Mouth Rinse on Salivary Streptococcus mutans in Children with Mixed Dentition: A Randomized Crossover Study. Int J Clin Pediatr Dent 2022;15(1):99-103.
目的
(某菌)对目前可用的抗生素和化疗药物的耐药性增强。本研究比较了洗必泰和草本漱口水对混合牙列期儿童唾液中(某菌)的疗效。
材料与方法
选取混合牙列期的受试者(n = 60)进行研究。使用尼瓦德标准记录龋病状况。收集基线唾液样本并评估以量化(某菌)数量。受试者被指示用0.2% w/v的洗必泰和草本漱口水漱口7天。7天后收集唾液样本并评估(某菌)数量。在21天的导入期后,根据拉丁方设计对两种漱口水进行交叉,然后进行类似的操作。随后,测定唾液样本中的平均菌落形成单位(CFU/mL)。对于统计分析,应用了柯尔莫哥洛夫检验和曼-惠特尼U检验。
结果
两组在基线时和7天时(某菌)计数均显著降低(P = 0.0001),与洗必泰漱口水相比,草本漱口水(某菌)计数降低(P = 0.0209)具有统计学意义。
结论
事实证明,草本漱口水比洗必泰漱口水具有更好的抗菌效果。
如何引用本文
Shah SV, Badakar CM, Hugar SM, 洗必泰和草本漱口水对混合牙列期儿童唾液变形链球菌的抗菌效果:一项随机交叉研究。《国际临床儿科牙科学杂志》2022;15(1):99 - 103。